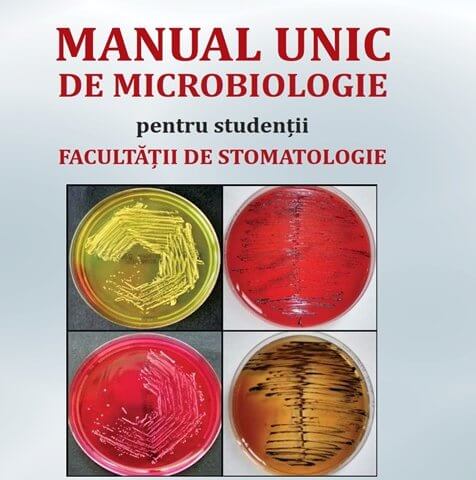

PRACTICAL GUIDE FOR MEDICAL PHYSIOLOGY 2nd Edition Revised and added
October 17, 2025
INCURSIUNE ÎN NEFROLOGIE (PENTRU MEDICI REZIDENŢI ŞI SPECIALIŞTI DE ALTE SPECIALITĂŢI)
October 17, 2025MANUAL UNIC DE MICROBIOLOGIE PENTRU STUDENȚII FACULTĂȚII DE STOMATOLOGIE
Autori: Andreea Cristiana Didilescu, Gabriela Băncescu.
Titlu: Manual unic de microbiologie pentru studenţii facultăţii de stomatologie
ISBN: 978-606-011-344-7
Apărut: Octombrie 2025
Pagini: 224
ISBN: 978‐606‐011‐344‐7
CUPRINS:
Lista de abrevieri
Capitolul 1. Introducere în microbiologie. Noțiuni de taxonomie microbiană. Clasificarea microorganismelor.
Capitolul 2. Definiția și morfologia bacteriilor.Structuri bacteriene obligatorii și facultative.
Capitolul 3. Noțiuni de fiziologie bacteriană. Curba de creștere și de înmulțire bacteriană. Noțiuni de genetică bacteriană.
Capitolul 4. Relațiile dintre bacterii și gazda umană. Factori și mecanisme de patogenitate bacteriană.Noțiuni privind apărarea antiinfecțioasă a gazdei.
Capitolul 5. Noțiuni privind produsele biologice cu rol în profilaxia și tratamentul unor boli infecțioase. Antibiotice: definiție, clasificare, mecanisme de acțiune. Principalele clase de antibiotice. Mecanisme de rezistență bacteriană la antibiotice.
Capitolul 6. Caracteristicile ecosistemului de la nivelul cavității orale. Microbiocenoza cavității bucale.Placa dentară: structură și etape de formare. Efectele biofilmelor orale.
Capitolul 7. Rolul plăcii bacteriene în producerea cariilor dentare și a parodontitelor. Specii/genuri de bacterii anaerobe nesporulate implicate în alte infecții orale: periimplantite, infecții endodontice și dentoalveolare.
Capitolul 8. Specii de coci Gram-pozitivi cu importanță medicală: caractere generale și infecții produse. Streptococii orali - aspecte legate de implicarea în patologie.
Capitolul 9. Specii de coci Gram-negativi cu importanță medicală: caractere generale și infecții produse. Bacterii spiralate întâlnite în cavitatea bucală. Specii de treponeme orale – implicații în patologia orală. T. pallidum – caractere generale și infecția produsă.
Capitolul 10. Grupul HACEK și specii/genuri de bacilli Gram-negativi aerobi și facultativ anaerobi, de larg interes pentru patologia umană - caractere generale și infecții produse
Capitolul 11. Specii de bacili Gram-pozitivi sporulați și nesporulați, bacilli acido-alcoolo-rezistenți și actinomicete: caractere generale și implicații în patologie.
Capitolul 12. Fungi ce pot fi întâlniți în cavitatea orală.Candida albicans- caractere generale și implicații în patologia orală. Protozoare cu habitat oral: Entamoeba gingivalis șiTrichomonas tenax–caractere generale și implicații în patologia orală. Alte exemple de paraziți și implicații în patologia umană.
Capitolul 13. Virusuri implicate în patologia umană: caractere generale, morfologie, structură și replicare. Relațiile virus-gazdă și noțiuni de patogenie a infecției virale. Agenții etiologici ai rinofaringitei virale acute, virusurile gripale, virusul rujeolei, virusul rubeolei și SARS-CoV-2: taxonomie, structură, căi de transmitere și infecții produse. Virusurile herpetice: taxonomie, structură, căi de transmitere și afecțiunile produse.
Capitolul 14. Stomatite virale – clasificare și virusuri implicate în patogenia acestora. Virusul imunodeficienței umane (HIV), Virusul hepatitei B și Virusul hepatitei C: taxonomie, structură, căi de transmitere și infecțiile produse. Semnificația markerilor imunologici în hepatita B. Surse și căi de transmitere ale microorganismelor în practica stomatologică.
Test grilă de tip complement simplu, pentru verificarea cunoștințelor.
Răspunsurile pentru testul grilă.
Legat de:
Anomaliile dentare și dento-maxilare


